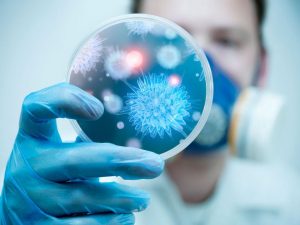

Un total de 176.500 toneladas métricas de microfibras sintéticas, principalmente poliéster y nailon, se liberan cada año en entornos terrestres en todo el mundo, según un nuevo estudio publicado en la revista de acceso abierto 'PLOS ONE' por Jenna Gavigan y sus colegas de la Universidad de California.
Las microfibras se desprenden de la ropa durante el lavado y la cantidad que termina en la tierra ahora excede la cantidad que llega a los cuerpos de agua.
La contaminación plástica en el océano ha recibido mucha atención en los últimos años, pero las vías fluviales no son el único lugar donde se acumula el plástico. El 14 por ciento de todo el plástico se usa para fabricar fibras sintéticas, principalmente para ropa.
Las microfibras, definidas como partículas de menos de 5 milímetros de longitud, se generan en grandes cantidades en cada etapa del ciclo de vida de una fibra, especialmente durante el lavado, que fragmenta mecánicamente las fibras sintéticas.
Cuando el agua de lavado pasa a formar parte del flujo hacia una planta de tratamiento de aguas residuales, las microfibras que contiene pueden retenerse junto con el lodo biosólido, que puede aplicarse a tierras de cultivo o enterrarse en vertederos.
Para comprender el alcance global y la distribución de la liberación de microfibras sintéticas, los autores recopilaron datos sobre la producción, el consumo y la liberación mundiales de plásticos, incorporando más datos sobre las microfibras liberadas durante el lavado tanto a máquina como a mano, y la acumulación y distribución de microfibras en plantas de tratamiento de aguas residuales y el destino de los lodos de aguas residuales que contienen gran parte de estos residuos plásticos.
Debido a que muchas regiones no tienen datos detallados sobre el tratamiento de aguas residuales, los autores se aproximaron cuando fue necesario para desarrollar una imagen completa, utilizando el ingreso medio como un indicador del grado probable de tratamiento de aguas residuales.
Los datos no representan las emisiones totales producidas por la ropa a lo largo de su vida útil. Por ejemplo, no se contabiliza la ropa de segunda mano.
Sin embargo, los cálculos de los autores mostraron que aproximadamente 5,6 millones de toneladas métricas de microfibras sintéticas se liberaron del lavado de ropa entre 1950, el comienzo del uso generalizado de fibras sintéticas, y 2016, la mitad en los últimos 10 años.
Poco menos de la mitad terminó en tierra, ya sea en la superficie (1,9 millones de toneladas métricas) o en vertederos (0,6 millones de toneladas métricas).
Las emisiones están creciendo un 12,9% anual y las emisiones anuales actuales a la tierra (176.500 toneladas métricas por año) superan a las de los cuerpos de agua (167.000 toneladas métricas por año).
"Es poco probable que la eliminación a gran escala de microfibras del medio ambiente sea técnicamente factible o económicamente viable, por lo que el enfoque debe estar en la prevención de emisiones --señala Gavigan--. Dado que las plantas de tratamiento de aguas residuales no necesariamente reducen las emisiones al medio ambiente, nuestro enfoque debe ser reducir las emisiones antes de que ingresen a la corriente de aguas residuales".